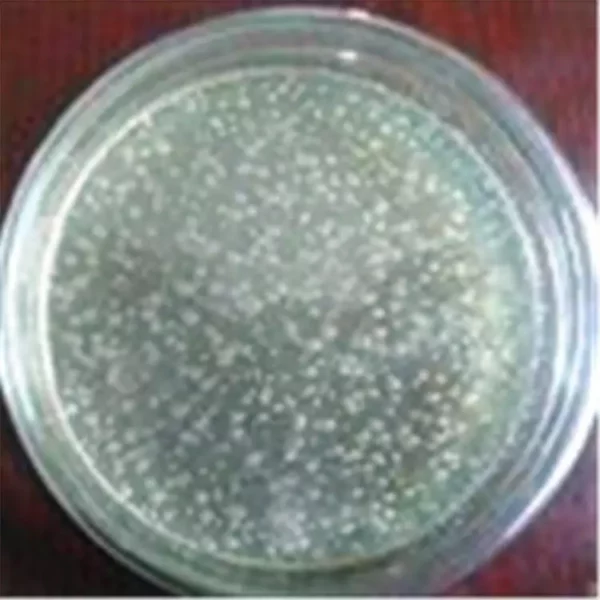

+86-18939199715
elma@agrichemistry.com

| Classification: | Biological Fertilizer |
| CAS No.: | NA |
| Other Names: | Biological Fertilizer |
| MF: | Mixture |
| EINECS No.: | EINECS |
Azotobacter Chroococcum Spp
Description:
The Azotobacter Chroococcum Spp is a aerobic ,free living soil microbes which could fixed nitrogen
ingredient from atmospheric and releasing it in the form of ammonium ions in to the soil.
Specification:
Effective microorganism account ≥ 0.2billion cfu/g
Package:
1/5-/10kg per Aluminum bag
Shelf Time:Two years



